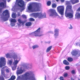
Proximidad de las células a los capilares

La hiperbilirrubinemia es la condición más común que requiere evaluación y tratamiento en los recién nacidos. La manifestación clínica de hiperbilirrubinemia -ictericia- ocurre en el 60% de los recién nacidos normales y en casi todos los prematuros.
Causas de hiperbilirrubinemia indirecta
- Hemolíticas
- Incompatibilidad ABO: madre tiene O y RN tiene A o B. Es lo más común en cuanto a etiología hemolítica pero no lo más agresivo.
- Enfermedad hemolítica por incompatibilidad Rh y subgrupos Rh.
- Es lo más agresivo. Ha disminuido mucho su prevalencia gracias a la implementación del Rhogam (gamaglobulina anti D).
- Esferocitosis familiar
- Déficit glucosa 6-P
- Déficit piruvato kinasa
- Alfa y beta talasemia
- Hemolisis inducida por medicamentos
- Causas no hemolíticas
- Aumento de la circulación enterohepática: hipoalimentación (evaluar precozmente la técnica de lactancia y que la madre se vaya segura), obstrucción intestinal (diafragmas duodenales, páncreas anular, Hirschsprung, íleo o tapón meconial y estenosis pilórica).
- Mayor producción de bilirrubina: poliglobulia (Hematocrito > 65%), reabsorción o destrucción de glóbulos rojos en lesiones traumáticas como cefalohematomas, hemorragia digestiva, hemorragia intracraneana, equimosis.
- Déficit de actividad glucoronil transferasa: Síndrome Crigler Najjar I y II, Síndrome de Gilbert.
- Disfunción hepática: asfixia, sepsis, shock, insuficiencia cardiaca, hepatitis.
- Enfermedades metabólicas: galactosemia, tirosinemia.
- Hipotiroidismo (por retardo en la maduración enzimática)
- Infección urinaria: sospechar en recién nacido mayor a 7 días de vida, que se encuentra ictérico, sin otros factores de riesgo de hiperbilirrubinemia. La ictericia puede ser el único síntoma y se debe considerar que puede aumentar también la bilirrubina directa.
Causas de hiperbilirrubinemia directa.
No son tan frecuentes pero su diagnóstico marca el pronóstico.
- Atresia de la vía biliar: cambia mucho su pronóstico si la cirugía es antes o después de los 2 meses (6 semanas), desde trasplante hepático hasta la muerte. Prevalencia 1: 10000.
- Hepatitis neonatal (1:5000)
- Déficit alfa-antitripsina (1:20000)
- Obstrucción del colédoco: se puede ver ictericia permanente o intermitente junto con coluria y acolia intermitente.
Fuente:
- Pérez Valenzuela, C., Perret Pérez, C. y Poblete Villacorta, M. (2019). Manual de pediatría. Santiago, Chile: Perret Pérez, Cecilia